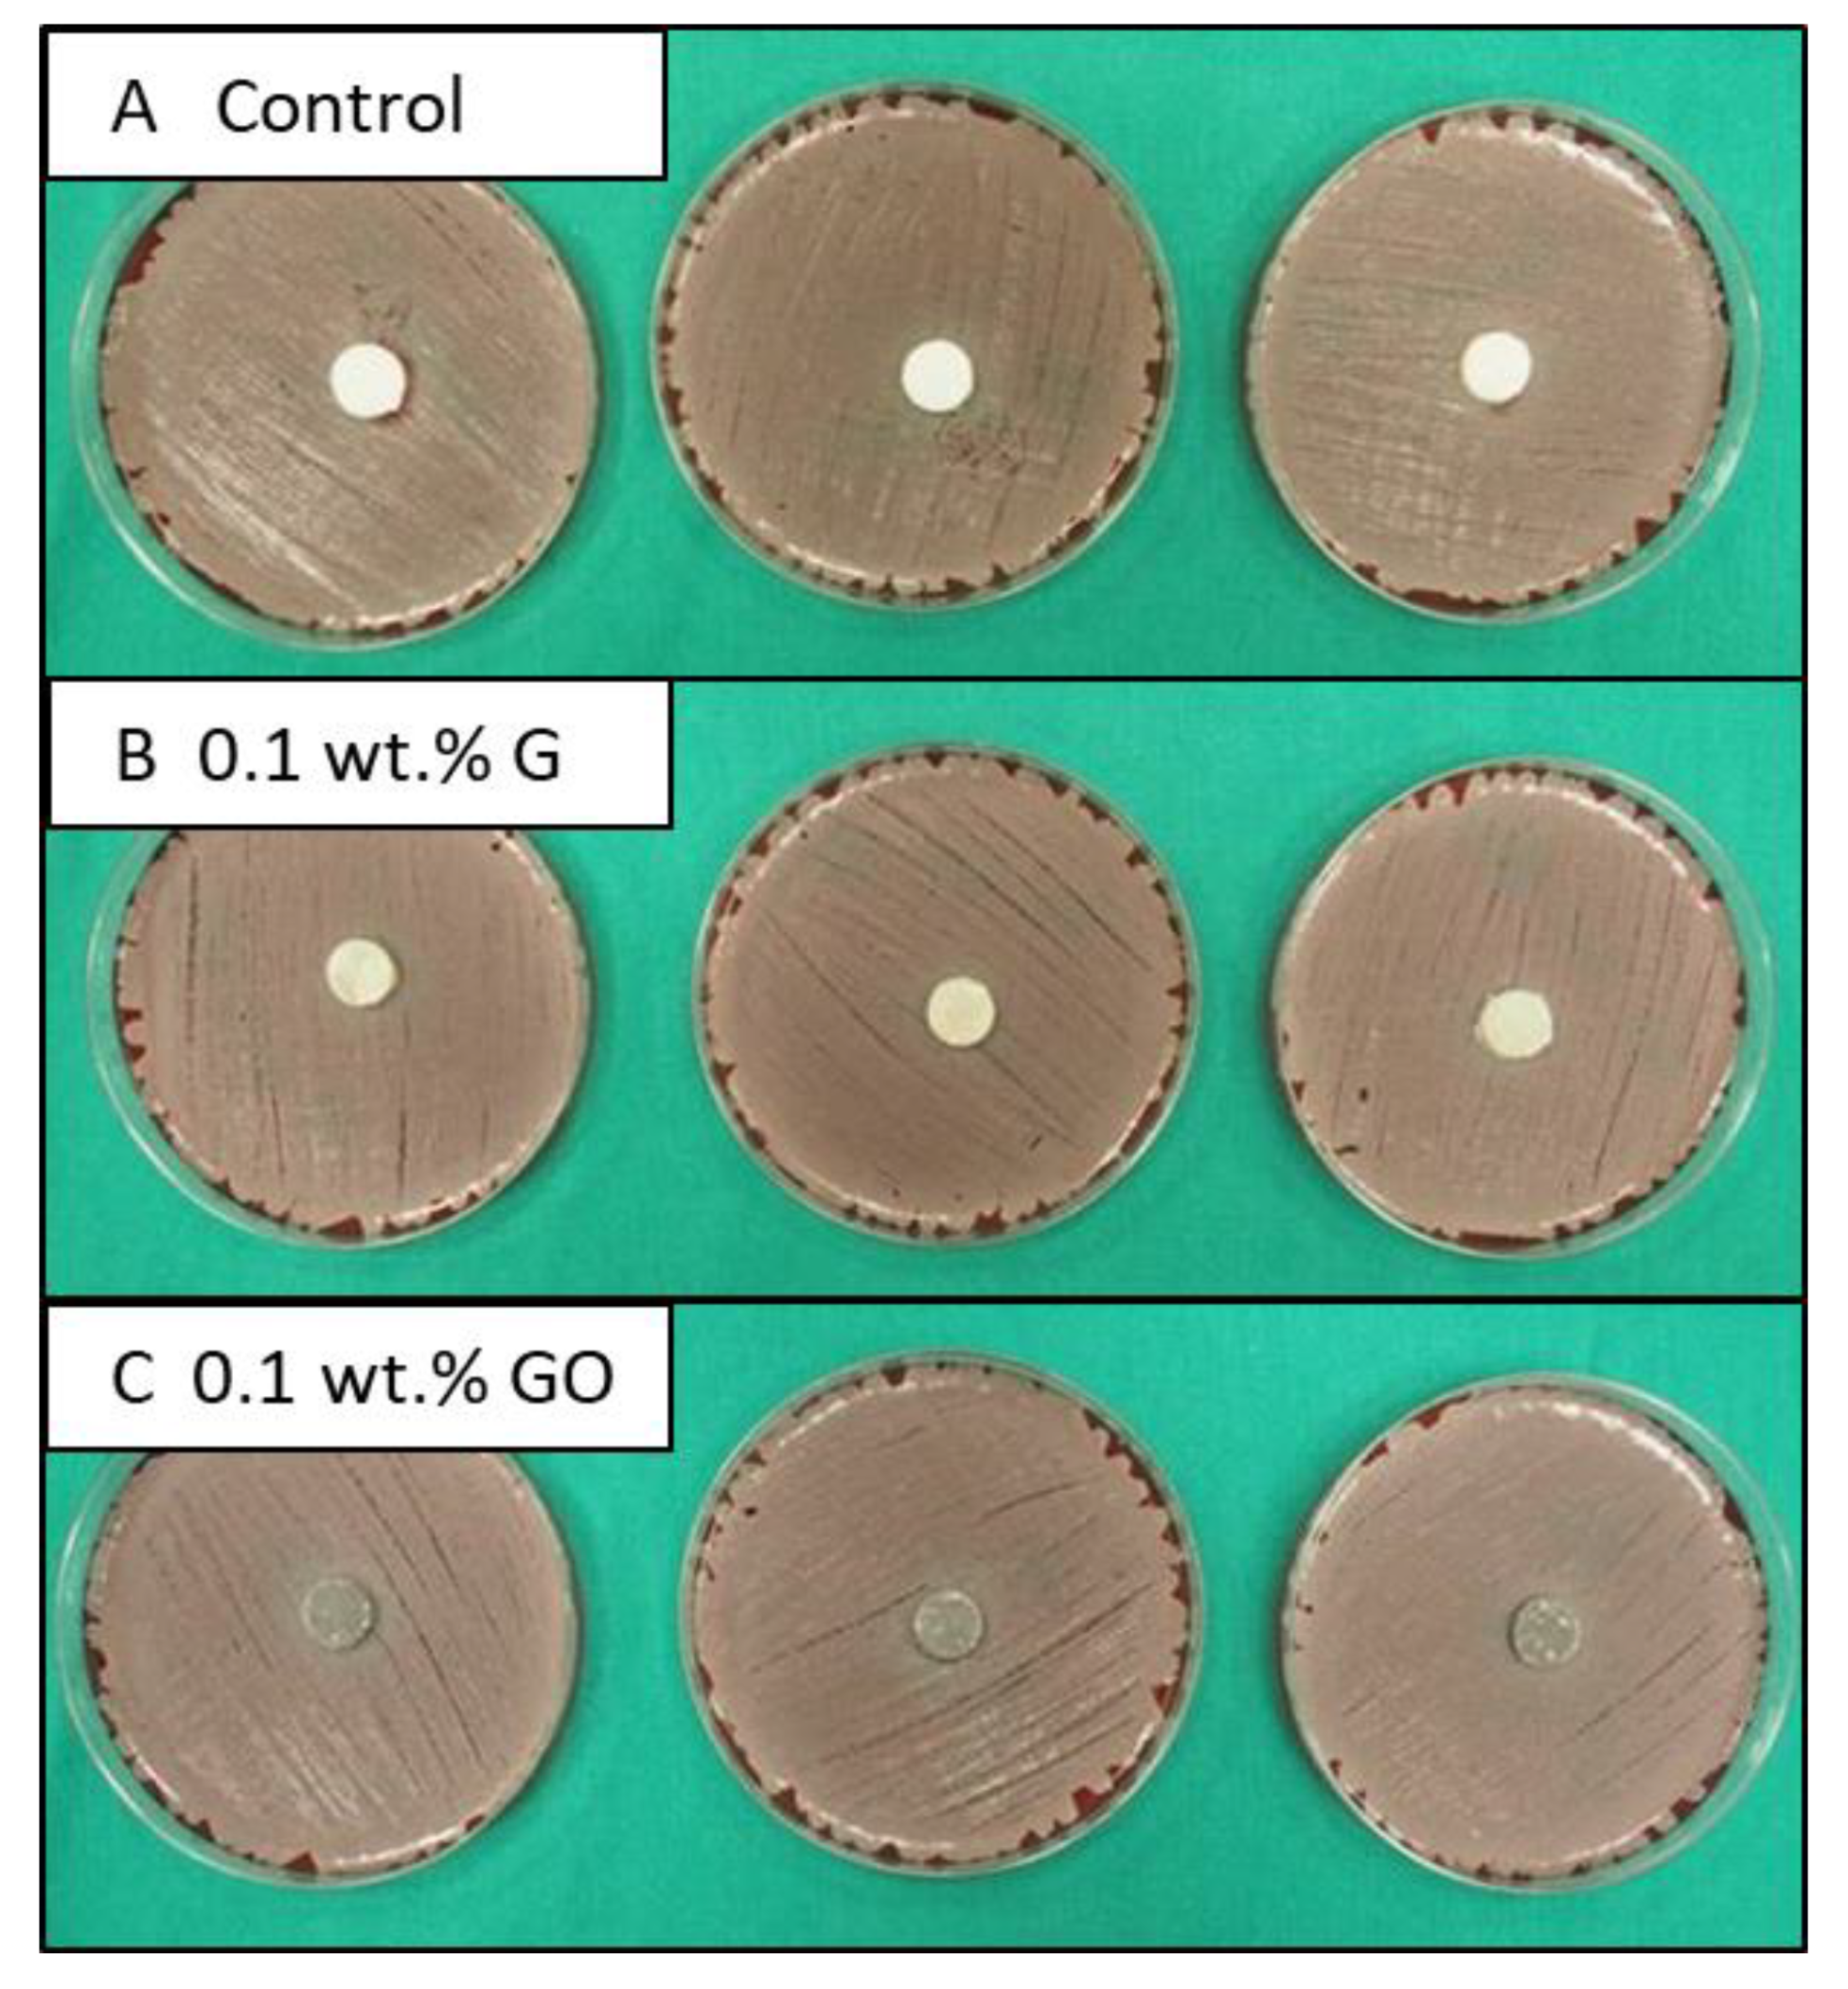
Materials 12 03146 g005 Materials 12 03146 g005

Graphene Oxide and Graphene Reinforced PMMA Bone Cements: Evaluation of Thermal Properties and Biocompatibility
Abstract
1. Introduction
2. Materials and Method
2.1. Materials
2.1.1. Nanomaterials
2.1.2. PMMA Bone Cement
2.2. Experimental Procedure
2.2.1. Differential Scanning Calorimetry (DSC)
Kinetic Analysis of Polymerisation Reaction
Glass Transition Temperature
Thermal Conductivity
2.2.2. Biocompatibility Tests and Antimicrobial Activity
2.2.3. Statistical Analysis
3. Results and Discussion
3.1. Kinetic of Polymerisation Reaction
3.2. Glass Transition Temperature and Thermal Conductivity
3.3. Cell Viability and Antimicrobial Activity
4. Conclusions
Author Contributions
Funding
Acknowledgments
Conflicts of Interest
References
- Dreyer, D.R.; Jia, H.P.; Bielawski, C.W. Graphene oxide: a convenient carbocatalyst for facilitating oxidation and hydration reactions. Angew. Chem. Int. Ed. 2010, 49, 6813–6816. [Google Scholar] [CrossRef]
- Geim, A.K.; Novoselov, K.S. The rise of graphene. Nat. Mater. 2007, 6, 183–191. [Google Scholar] [CrossRef] [PubMed]
- Zhang, B.T.; Zheng, X.; Li, H.F.; Lin, J.M. Application of carbon-based nanomaterials in sample preparation: A review. Anal. Chim. Acta 2013, 784, 1–17. [Google Scholar] [CrossRef] [PubMed]
- Potts, J.R.; Dreyer, D.R.; Bielawski, C.W.; Ruoff, R.S. Graphene-based polymer nanocomposites. Polymer 2011, 52, 5–25. [Google Scholar] [CrossRef]
- Balandin, A.A. Thermal properties of graphene and nanostructured carbon materials. Nat. Mater. 2011, 10, 569–581. [Google Scholar] [CrossRef] [PubMed]
- Nika, D.L.; Balandin, A.A. Phonons and thermal transport in graphene and graphene-based materials. Rep. Prog. Phys. 2017, 80, 036502. [Google Scholar] [CrossRef] [PubMed]
- Liu, S.; Zeng, T.H.; Hofmann, M.; Burcombe, E.; Wei, J.; Jiang, R.; Kong, J.; Chen, Y. Antibacterial activity of graphite, graphite oxide, graphene oxide, and reduced graphene oxide: membrane and oxidative stress. ACS Nano 2011, 5, 6971–6980. [Google Scholar] [CrossRef] [PubMed]
- Santos, C.M.; Mangadlao, J.; Ahmed, F.; Leon, A.; Advincula, R.C.; Rodrigues, D.F. Graphene nanocomposite for biomedical applications: fabrication, antimicrobial and cytotoxic investigations. Nanotechnology 2012, 23, 395101. [Google Scholar] [CrossRef] [PubMed]
- Chandrasekaran, S.; Sato, N.; Tölle, F.; Mülhaupt, R.; Fiedler, B.; Schulte, K. fracture toughness and failure mechanism of graphene based epoxy composites. Compos. Sci. Technol. 2014, 97, 90–99. [Google Scholar] [CrossRef]
- Li, Z.; Young, R.J.; Wang, R.; Yang, F.; Hao, L.; Jiao, W.; Liu, W. The role of functional groups on graphene oxide in epoxy nanocomposites. Polymer 2013, 54, 5821–5829. [Google Scholar] [CrossRef]
- Paz, E.; Forriol, F.; del Real, J.C.; Dunne, N. Graphene oxide versus graphene for optimisation of pmma bone cement for orthopaedic applications. Mater. Sci. Eng. C 2017, 77, 1003–1011. [Google Scholar] [CrossRef] [PubMed]
- Paz, E.; Ballesteros, Y.; Forriol, F.; Dunne, N.J.; del Real, J.C. Graphene and graphene oxide functionalisation with silanes for advanced dispersion and reinforcement of PMMA-based bone cements. Mater. Sci. Eng. C 2019, 104, 109946. [Google Scholar] [CrossRef] [PubMed]
- Dunne, N.J.; Orr, J.F. Curing characteristics of acrylic bone cement. J. Mater. Sci. Mater. Med. 2002, 13, 17–22. [Google Scholar] [CrossRef] [PubMed]
- Jefferiss, C.D.; Lee, A.J.C.; Ling, R.S.M. Thermal aspects of self-curing polymethylmethacrylate. J. Bone Jt. Surg. Br. 1975, 57-B, 511–518. [Google Scholar]
- Berman, A.T.; Spence, J.R.; Yanicko, D.R.; Sih, G.C.; Zimmerman, M.R. Thermally induced bone necrosis in rabbits: relation to implant failure in humans. Clin. Orthop. Relat. Res. 1984, 186, 284–292. [Google Scholar] [CrossRef]
- Starke, G.R.; Birnie, C.; van den Blink, P.A. Numerical modelling of cement polymerisation and thermal bone necrosis. In Computer Methods in Biomechanics and Biomedical Engineering; Middleton, J., Jones, M.L., Pande, G.N., Eds.; Gordon and Breach Science Publishers: New York, NY, USA, 1999; Volume 2, pp. 163–172. [Google Scholar]
- Ormsby, R.; McNally, T.; Mitchell, C.; Halley, P.; Martin, D.; Nicholson, T.; Dunne, N. Effect of MWCNT addition on the thermal and rheological properties of polymethyl methacrylate bone cement. Carbon 2011, 49, 2893–2904. [Google Scholar] [CrossRef]
- Gonçalves, G.; Cruz, S.M.A.; Ramalho, A.; Grácio, J.; Marques, P.A.A.P. Graphene oxide versus functionalized carbon nanotubes as a reinforcing agent in a PMMA/HA bone cement. Nanoscale 2012, 4, 2937–2945. [Google Scholar] [CrossRef]
- Marrs, B.; Andrews, R.; Rantell, T.; Pienkowski, D. Augmentation of acrylic bone cement with multiwall carbon nanotubes. J. Biomed. Mater. Res. A 2006, 77A, 269–276. [Google Scholar] [CrossRef]
- Fan, H.; Wang, L.; Zhao, K.; Li, N.; Shi, Z.; Ge, Z.; Jin, Z. Fabrication, mechanical properties, and biocompatibility of graphene-reinforced chitosan composites. Biomacromolecules 2010, 11, 2345–2351. [Google Scholar] [CrossRef]
- Guo, X.; Mei, N. Assessment of the toxic potential of graphene family nanomaterials. J. Food Drug Anal. 2014, 22, 105–115. [Google Scholar] [CrossRef]
- Liao, K.H.; Lin, Y.S.; Macosko, C.W.; Haynes, C.L. Cytotoxicity of graphene oxide and graphene in human erythrocytes and skin fibroblasts. ACS Appl. Mater. Interfaces 2011, 3, 2607–2615. [Google Scholar] [CrossRef]
- Pinto, A.M.; Gonçalves, I.C.; Magalhães, F.D. Graphene-based materials biocompatibility: A review. Colloids Surf. B Biointerfaces 2013, 111, 188–202. [Google Scholar] [CrossRef] [PubMed]
- Singh, Z.S. Applications and toxicity of graphene family nanomaterials and their composites. Nanotechnol. Sci. Appl. 2016, 15. [Google Scholar] [CrossRef] [PubMed]
- Hu, W.; Peng, C.; Luo, W.; Lv, M.; Li, X.; Li, D.; Huang, Q.; Fan, C. Graphene-based antibacterial paper. ACS Nano 2010, 4, 4317–4323. [Google Scholar] [CrossRef] [PubMed]
- Krishnamoorthy, K.; Umasuthan, N.; Mohan, R.; Lee, J.; Kim, S.J. Antibacterial activity of graphene oxide nanosheets. Sci. Adv. Mater. 2012, 4, 1111–1117. [Google Scholar] [CrossRef]
- Perreault, F.; de Faria, A.F.; Nejati, S.; Elimelech, M. Antimicrobial properties of graphene oxide nanosheets: why size matters. ACS Nano 2015, 9, 7226–7236. [Google Scholar] [CrossRef] [PubMed]
- Ormsby, R.; McNally, T.; Mitchell, C.; Dunne, N. Influence of multiwall carbon nanotube functionality and loading on mechanical properties of PMMA/MWCNT bone cements. J. Mater. Sci. Mater. Med. 2010, 21, 2287–2292. [Google Scholar] [CrossRef] [PubMed]
- Abenojar, J.; Martínez, M.A.; Pantoja, M.; Velasco, F.; Real, J.C.D. Epoxy composite reinforced with nano and micro sic particles: curing kinetics and mechanical properties. J. Adhes. 2012, 88, 418–434. [Google Scholar] [CrossRef]
- Vyazovkin, S.; Wight, C.A. Model-free and model-fitting approaches to kinetic analysis of isothermal and nonisothermal data. Thermochim. Acta 1999, 340–341, 53–68. [Google Scholar] [CrossRef]
- Hakvoort, G.; van Reijen, L.L.; Aartsen, A.J. Measurement of the thermal conductivity of solid substances by DSC. Thermochim. Acta 1985, 93, 317–320. [Google Scholar] [CrossRef]
- Camirand, C.P. Measurement of thermal conductivity by differential scanning calorimetry. Thermochim. Acta 2004, 417, 1–4. [Google Scholar] [CrossRef]
- Vallo, C.I. Residual monomer content in bone cements based on poly (methyl methacrylate). Polym. Int. 2000, 49, 831–838. [Google Scholar] [CrossRef]
- Borzacchiello, A.; Ambrosio, L.; Nicolais, L.; Harper, E.J.; Tanner, K.E.; Bonfield, W. Isothermal and non-isothermal polymerization of a new bone cement. J. Mater. Sci. Mater. Med. 1998, 9, 317–324. [Google Scholar] [CrossRef] [PubMed]
- Yang, J.M.; Shyu, J.S.; Chen, H.L. Polymerization of acrylic bone cement investigated by differential scanning calorimetry: effects of heating rate and TCP content. Polym. Eng. Sci. 1997, 37, 1182–1187. [Google Scholar] [CrossRef]
- Hasenwinkel, J.M.; Lautenschlager, E.P.; Wixson, R.L.; Gilbert, J.L. Effect of initiation chemistry on the fracture toughness, fatigue strength, and residual monomer content of a novel high-viscosity, two-solution acrylic bone cement. J. Biomed. Mater. Res. 2002, 59, 411–421. [Google Scholar] [CrossRef] [PubMed]
- Lewis, G.; van Hooy-Corstjens, C.S.J.; Bhattaram, A.; Koole, L.H. Influence of the radiopacifier in an acrylic bone cement on its mechanical, thermal, and physical properties: barium sulfate-containing cement versus iodine-containing cement. J. Biomed. Mater. Res. B Appl. Biomater. 2005, 73B, 77–87. [Google Scholar] [CrossRef] [PubMed]
- Biondi, M.; Borzacchiello, A.; Netti, P.A. Isothermal and non-isothermal polymerization of methyl methacrylate in presence of multiple initiators. Chem. Eng. J. 2010, 162, 776–786. [Google Scholar] [CrossRef]
- Dunne, N.J.; Orr, J.F. Thermal characteristics of curing acrylic bone cement. ITBM-RBM 2001, 22, 88–97. [Google Scholar] [CrossRef]
- Cardenas, J.N.; O’Driscoll, K.F. High-conversion polymerization. I. theory and application to methyl methacrylate. J. Polym. Sci. Polym. Chem. Ed. 1976, 14, 883–897. [Google Scholar] [CrossRef]
- Barbosa, A.Q.; da Silva, L.F.M.; Abenojar, J.; del Real, J.C.; Paiva, R.M.M.; Öchsner, A. Kinetic analysis and characterization of an epoxy/cork adhesive. Thermochim. Acta 2015, 604, 52–60. [Google Scholar] [CrossRef]
- Navalon, S.; Dhakshinamoorthy, A.; Alvaro, M.; Antonietti, M.; García, H. Active sites on graphene-based materials as metal-free catalysts. Chem. Soc. Rev. 2017, 46, 4501–4529. [Google Scholar] [CrossRef]
- Xing, W.; Li, H.; Huang, G.; Cai, L.H.; Wu, J. Graphene oxide induced crosslinking and reinforcement of elastomers. Compos. Sci. Technol. 2017, 144, 223–229. [Google Scholar] [CrossRef]
- Zhu, Z.; Shi, S.; Wang, H. Radical chain polymerization catalyzed by graphene oxide and cooperative hydrogen bonding. Macromol. Rapid Commun. 2016, 37, 187–194. [Google Scholar] [CrossRef] [PubMed]
- Abenojar, J.; Tutor, J.; Ballesteros, Y.; del Real, J.C.; Martínez, M.A. Erosion-wear, mechanical and thermal properties of silica filled epoxy nanocomposites. Compos. Part B Eng. 2017, 120, 42–53. [Google Scholar] [CrossRef]
- Abenojar, J.; del Real, J.C.; Ballesteros, Y.; Martinez, M.A. Kinetics of curing process in carbon/epoxy nano-composites. IOP Conf. Ser. Mater. Sci. Eng. 2018, 369, 012011. [Google Scholar] [CrossRef]
- Abenojar, J.; Encinas, N.; del Real, J.C.; Martínez, M.A. Polymerization kinetics of boron carbide/epoxy composites. Thermochim. Acta 2014, 575, 144–150. [Google Scholar] [CrossRef]
- Palagummi, S.V.; Landis, F.A.; Chiang, M.Y.M. Real-Time synchronous measurement of curing characteristics and polymerization stress in bone cements with a cantilever-beam based instrument. Rev. Sci. Instrum. 2018, 89, 035102. [Google Scholar] [CrossRef] [PubMed]
- Valencia Zapata, M.E.; Mina Hernandez, J.H.; Grande Tovar, C.D.; Valencia Llano, C.H.; Diaz Escobar, J.A.; Vazquez-Lasa, B.; San Roman, J.; Rojo, L. Novel bioactive and antibacterial acrylic bone cement nanocomposites modified with graphene oxide and chitosan. Int. J. Mol. Sci. 2019, 20, 2938. [Google Scholar] [CrossRef]
- Liao, K.H.; Aoyama, S.; Abdala, A.A.; Macosko, C. Does graphene change Tg of nanocomposites? Macromolecules 2014, 47, 8311–8319. [Google Scholar] [CrossRef]
- Ramanathan, T.; Stankovich, S.; Dikin, D.A.; Liu, H.; Shen, H.; Nguyen, S.T.; Brinson, L.C. Graphitic nanofillers in PMMA nanocomposites—An investigation of particle size and dispersion and their influence on nanocomposite properties. J. Polym. Sci. Part B Polym. Phys. 2007, 45, 2097–2112. [Google Scholar] [CrossRef]
- Graphene-based Nanocomposites as Highly Efficient Thermal Interface Materials. Available online: https://arxiv.org/abs/1201.0796 (accessed on 1 August 2019).
- Kim, H.; Abdala, A.A.; Macosko, C.W. Graphene/polymer nanocomposites. Macromolecules 2010, 43, 6515–6530. [Google Scholar] [CrossRef]
- Ramirez, S.; Chan, K.; Hernandez, R.; Recinos, E.; Hernandez, E.; Salgado, R.; Khitun, A.G.; Garay, J.E.; Balandin, A.A. Thermal and magnetic properties of nanostructured densified ferrimagnetic composites with graphene-graphite fillers. Mater. Des. 2017, C (118), 75–80. [Google Scholar] [CrossRef]
- Kargar, F.; Barani, Z.; Balinskiy, M.; Magana, A.S.; Lewis, J.S.; Balandin, A.A. Dual-functional graphene composites for electromagnetic shielding and thermal management. Adv. Electron. Mater. 2019, 5, 1800558. [Google Scholar] [CrossRef]
- Gonçalves, G.; Portolés, M.T.; Ramírez-Santillán, C.; Vallet-Regí, M.; Serro, A.P.; Grácio, J.; Marques, P.A.A.P. Evaluation of the in vitro biocompatibility of PMMA/High-load HA/Carbon nanostructures bone cement formulations. J. Mater. Sci. Mater. Med. 2013, 24, 2787–2796. [Google Scholar] [CrossRef] [PubMed]

| Rate (°C/min) | ΔHc (J/mol) | ΔHR (J/mol) | ||||
|---|---|---|---|---|---|---|
| 5 | 10 | 20 | 5 | 10 | 20 | |
| Control | 81.91 | 82.80 | 82.41 | 4.82 | 5.32 | 4.98 |
| 0.1 wt.% G | 84.49 | 83.90 | 84.05 | 5.01 | 5.36 | 5.10 |
| 0.1 wt.% GO | 84.60 | 84.49 | 85.42 | 5.37 | 5.42 | 5.27 |
| Properties | Control | G | GO | |||
|---|---|---|---|---|---|---|
| Temperature (°C) | 25 | 35 | 25 | 35 | 25 | 35 |
| Conversion Degree (%) | Time (min) | Time (min) | Time (min) | |||
| 5 | 18.06 | 5.11 | 8.56 | 3.83 | 10.19 | 3.11 |
| 10 | 19.65 | 5.94 | 9.89 | 4.49 | 11.66 | 4.53 |
| 20 | 20.58 | 6.75 | 11.76 | 5.35 | 13.64 | 5.19 |
| 30 | 20.91 | 7.23 | 13.23 | 6.00 | 14.41 | 5.66 |
| 40 | 21.03 | 7.60 | 14.50 | 6.55 | 15.18 | 6.14 |
| 50 | 21.03 | 7.90 | 15.74 | 7.05 | 15.95 | 6.61 |
| 60 | 21.03 | 8.16 | 17.17 | 7.59 | 17.08 | 7.09 |
| 70 | 21.03 | 8.33 | 19.21 | 8.30 | 18.70 | 7.57 |
| 80 | 21.03 | 8.50 | 25.04 | 10.33 | 25.49 | 10.02 |
| 90 | 21.04 | 9.27 | 89.26 | 30.86 | 659.43 | 100.12 |
| 94 | 21.04 | 10.72 | 164.93 | 59.01 | - | 2008.7 |
| Cement | Glass Transition Temperature, Tg | Thermal Conductivity, λ | ||||
|---|---|---|---|---|---|---|
| Tg (°C) | Difference (%) | p-Value | λ (W/m·°C) | Difference (%) | p-Value | |
| Control | 108.6 ± 0.4 | 0.176 ± 0.015 | ||||
| 0.1 wt.% G | 106.4 ± 1.6 | −2.0 | 0.0852 | 0.195 ± 0.023 | 10.9 | 0.1981 |
| 0.1 wt.% GO | 108.7 ± 0.2 | 0.1 | 0.7049 | 0.173 ± 0.011 | −1.8 | 0.0963 |
| Cell viability | Control | G | GO |
|---|---|---|---|
| Number of cells (± SD) | 6229 ± 556 | 5752 ± 21 | 4451 ± 107 |
| Difference vs. control (%) | −7.7 | −28.6 | |
| p-value | 0.995 | 0.454 |
© 2019 by the authors. Licensee MDPI, Basel, Switzerland. This article is an open access article distributed under the terms and conditions of the Creative Commons Attribution (CC BY) license (http://creativecommons.org/licenses/by/4.0/).
Share and Cite
Paz, E.; Ballesteros, Y.; Abenojar, J.; del Real, J.C.; Dunne, N.J. Graphene Oxide and Graphene Reinforced PMMA Bone Cements: Evaluation of Thermal Properties and Biocompatibility. Materials 2019, 12, 3146. https://doi.org/10.3390/ma12193146
Paz E, Ballesteros Y, Abenojar J, del Real JC, Dunne NJ. Graphene Oxide and Graphene Reinforced PMMA Bone Cements: Evaluation of Thermal Properties and Biocompatibility. Materials. 2019; 12(19):3146. https://doi.org/10.3390/ma12193146
Chicago/Turabian StylePaz, E., Y. Ballesteros, J. Abenojar, J.C. del Real, and N.J. Dunne. 2019. "Graphene Oxide and Graphene Reinforced PMMA Bone Cements: Evaluation of Thermal Properties and Biocompatibility" Materials 12, no. 19: 3146. https://doi.org/10.3390/ma12193146
APA StylePaz, E., Ballesteros, Y., Abenojar, J., del Real, J. C., & Dunne, N. J. (2019). Graphene Oxide and Graphene Reinforced PMMA Bone Cements: Evaluation of Thermal Properties and Biocompatibility. Materials, 12(19), 3146. https://doi.org/10.3390/ma12193146

